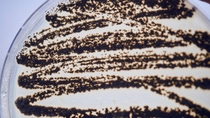

Media
The Science
Protecting crops from disease is essential if we are to sustainably improve yield on existing arable land to feed a growing population. How do BASF scientists develop products that are effective and safe for people and the environment? We follow the journey from lab to market.
Our drive throughout was the desire to support farmers in growing food in a better way. Seeing Revysol become such a success has been very rewarding.”
It looks like a normal greenhouse, but many of the plants appear to be on their last legs, leaves wilting and discolored. It’s no wonder – they have all been inoculated with pathogens that cause fungal diseases.
This is BASF’s fungicide greenhouse at Limburgerhof, Germany, where new active ingredients are tested on crops such as wheat, soybeans, lettuce and tomatoes to see if they are effective. If one looks promising because it appears to protect or cure a plant of fungal infection, the active ingredient is further developed and goes into field testing.
“Modern farming relies on high yields to secure the supply of high-quality food. Fungal diseases significantly decrease yields and have a negative impact on food quality,” says Klaas Lohmann, PhD, Principal Scientist Fungicide Chemistry at BASF.
Fungal infections pose a high risk of devastating harvests. That is why farmers rely on fungicides to control these diseases.”

Maintaining efficacy
Over time, however, many pathogens that cause disease can develop a resistance to the active ingredient. As older crop protection products become less effective, there is a constant need to innovate. But crop protection products also have to meet increasingly stringent environmental and safety requirements to prove that they are safe for people, animals and the environment.
“It is a major challenge. Our task is to find new active ingredients that lessen the fungal pressure on crops and are safe for humans and the environment,” says Lohmann. “They also have to be practical and easy for farmers to use.”
It is only through a sophisticated funneling process that this task can be fulfilled. It takes around 10 years to bring a new crop protection product to market. The successful development of the new fungicide Revysol®, for example, was the end of a research and development journey that began in Lohmann’s lab in the mid-2000s with the targeted screening of over 4,000 possible candidate molecules. In the end, only one complied with all the requirements.
“We start by screening compounds in the lab and then the greenhouse for activity. When we find something promising, the next step is to understand how it works,” says Lohmann. If it is genuinely new, he and his colleague design and synthesize similar molecules to find the one with the best performance.

Finding sustainable solutions
As the project develops, agronomists, biologists, toxicologists and engineers are brought on board, as well as experts such as Martin Dust, PhD, Head of Global Regulatory Affairs Fungicides at BASF. “From very early on we pay attention to the safety and sustainability of our products. In the discovery phase of Revysol, we used new indicator studies to increase the chances of meeting both the highest regulatory standards and outstanding biological performance,” says Dust. “New products have to pass the toughest tests to gain approval, particularly in Europe. For Revysol we conducted more than 290 studies comprehensively examining safety for humans and the environment.”
In the discovery phase of Revysol, we used new indicator studies to meet both the highest regulatory standards and outstanding biological performance.”
Given these strict requirements and the increasing cost of development, in the European Union there are now fewer active ingredients authorized for use, and few new active ingredients being submitted for approval.
With Revysol, Lohmann and his team have developed a highly effective fungicide that not only meets these strict requirements but is also practical and uniquely flexible. “What makes Revysol so special is that it controls many different fungal pathogens even where mutations have developed. It works both on row crops like wheat and corn, and on fruit and vegetables,” says Lohmann. “Farmers will therefore benefit from Revysol to safeguard their harvest.”
In the careers of both Lohmann and Dust, the achievements of the Revysol project stand out. “Discovering a new fungicide involves constantly deciding which path to pursue. Even after many years of development you can end up in a dead end,” says Lohmann. “There is no blueprint to follow – the correct intuition plays a role alongside rationality and hard work in almost every scientific discovery.”
Motivation also plays a key role. “Our drive throughout was the desire to support farmers in growing food in a better way,” says Dust. “Seeing Revysol become such a success has been very rewarding.”
Prescreening lab at BASF
Automated testing in the prescreening lab enables scientists to test up to 100,000 substances a year. After initial screening, substances are then tested on plants in the greenhouse. The results indicate the direction that further research should take.
What makes Revysol so special is that it controls many different fungal pathogens even where mutations have developed.”